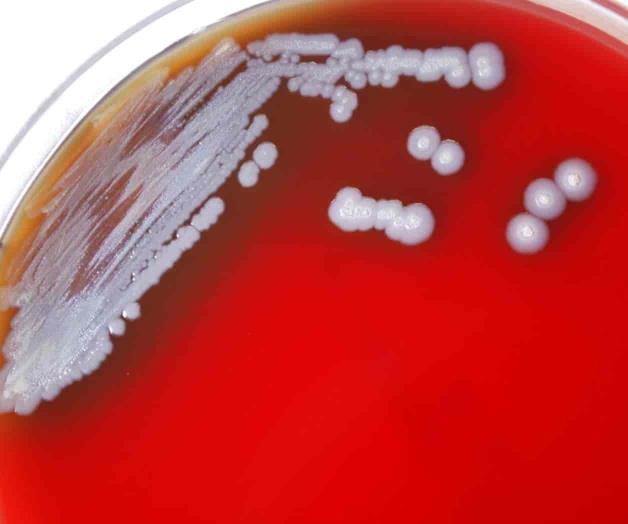
Detectan en EEUU bacteria que causa melioidosis

Detectan en EEUU bacteria que causa melioidosis
Un germen que causa una enfermedad rara y a veces fatal ha sido hallado en suelo y agua de Estados Unidos, dijeron funcionarios federales de salud
Esta foto proporcionada por los Centros para el Control y la Prevención de Enfermedades (CDC, por sus siglas en inglés) muestra varias colonias de la bacteria burkholderia pseudomallei, que puede causar melioidosis, una enfermedad rara y a veces fatal que se pensaba estaba confinada a climas tropicales.
NUEVA YORK
Un germen que causa una enfermedad rara y a veces fatal —el cual se pensaba estaba confinado a climas tropicales — ha sido hallado en suelo y agua de Estados Unidos, dijeron funcionarios federales de salud.
La bacteria fue encontrada en la propiedad de un hombre de Mississippi que había contraído la enfermedad, melioidosis. Las autoridades no saben cuánto tiempo había estado allí, pero dicen que probablemente está presente en otras áreas del Golfo de México.
Los médicos estadounidenses deberían considerar la posibilidad de la presencia de melioidosis incluso en pacientes que no han viajado a otros países, dijeron los Centros para el Control y la Prevención de Enfermedades (CDC, por sus siglas en inglés) en una alerta sanitaria.
“Una vez que está en el suelo, puede ser una amenaza para la salud de la gente en el área”, dijo Julia Petras, de los CDC, que supervisó la investigación.
La enfermedad puede empezar con una vasta gama de síntomas como fiebre, dolores en las articulaciones y de cabeza. Es tratable con los antibióticos correctos si es detectada temprano, pero puede derivar en neumonía, infecciones sanguíneas e incluso la muerte si no es tratada adecuadamente.
Cada año se reportan unos 12 casos en Estados Unidos. La gran mayoría han sido personas que viajaron a países en los que la bacteria es endémica, incluyendo ciertas regiones de Australia, Tailandia y América Central y del Sur.
Las personas pueden contraer la enfermedad a través de contacto directo con suelo y agua contaminados, especialmente si tienen una herida en una mano o un pie
Esta pudiera no afectar a las personas saludables, pero puede ser peligrosa para aquellas con diabetes, enfermedades renales o pulmonares crónicas y problemas inmunológicos.
El año pasado, cuatro personas contrajeron la enfermedad pese a que ninguna de ellas había viajado internacionalmente. Las autoridades atribuyeron su enfermedad a un rociador de aromaterapia importado de la India.
El nuevo hallazgo explica dos casos en Mississippi en hombres que no habían viajado, dijeron funcionarios. Uno contrajo melioidosis en el 2020, y el otro, que vive a unos 16 kilómetros (10 millas) del primero, se contagió este año. Ambos se recuperaron.
Las autoridades de salud no dijeron exactamente en qué parte de Mississippi viven los hombres, pero los investigadores tomaron 109 muestras de suelo y agua del área. La bacteria fue hallada en tres sitios —dos en el suelo y uno en el agua— en la propiedad del individuo que se enfermó hace dos años.
El descubrimiento de la bacteria en Estados Unidos es significativo, pero no sorprendente. Desde hace tiempo los investigadores consideran que la contaminación del suelo local fue causa de infecciones en el condado texano Atascosa en 2004 y 2018, dijeron funcionarios de los CDC.
